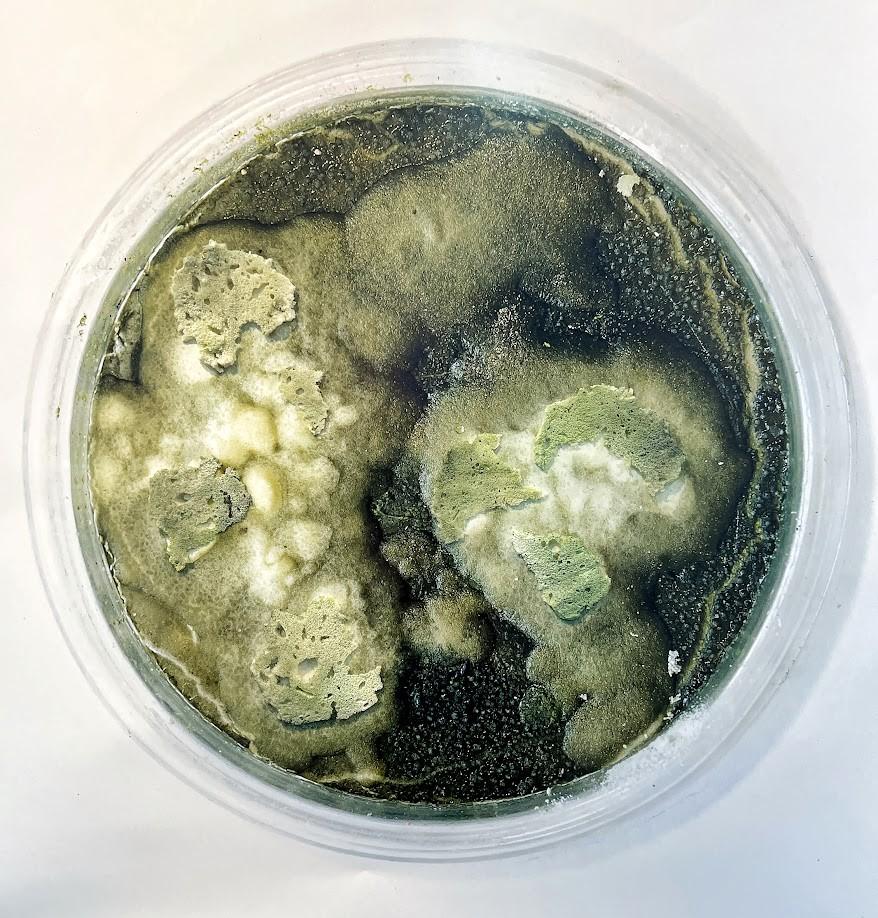

JUNE 2024


JUNE 2024

All information correct at time of publishing. Please phone or email relevant galleries to confirm dates of events as they may be subject to change.
Published by Corrie Scott corriescott@gmail.com A completely free magazine created out of the need to inform so that we can get to exhibitions, artist talks, workshops and more, rather than hearing about events after they have taken place.
Cover art Lineisha InceThirteen years of the publication
All issues
https://issuu.com/corriescott
This is a completely free magazine created out of the need to inform so that we can get to exhibitions, artist talks, workshops and more, rather than hearing about events after they have taken place.
I encourage anyone with a visual arts event to get in contact with me at corriescott@gmail.com and I will add a free page for your exhibition, classes, workshops, talks etc.
Let’s get the arts out there!
Please, pass this magazine on to others and so help the creative side of Barbados get all the exposure possible.
Corrie Scott PublisherCelebrating 14 years of Monthly Publications Covering the Visual Arts in Barbados

https://www.facebook.com/groups/175529135827747
Instagram.
@visualartsbarbadosevents
Visualartsbarbadosevents

The Barbados Arts Events page was created to promote the Visual Arts Events in Barbados and artists whether exhibiting here in island or overseas.
The focus is on the events for the fine arts, encompassing art, photography, sculpture and installations, gallery receptions, exhibitions, talks, interviews, workshops, publications, studios, residencies.
I will also post visual art collaborations with writers, theatre, dance, videos, music and creatives but it has to encompass the visual arts/artists to be posted on this page.
I started this page because I felt that the visual arts were not getting much needed exposure to expose the talent in Barbados and around the world. I wish I could encompass all the creative arts as there is so much happening on this tiny wonderful island of ours but I am a one woman band doing this free. Over the years this page has become a support for all creative events in Barbados and I was happy for this but realised that it was diluting the fine arts section which it is meant to focus on.
I need to bring the focus back in these group pages to the visual arts.
Thank you for understanding.
Corrie Scott

Fresh Milk offered cash prizes to the top performing students Lyneisha Ince and Ameome Ross.
“Continuing our commitment to supporting Barbados Community College (BCC) @bccvisualarts and the creativity and talent its Division of Fine Arts produces every year, Fresh Milk was excited to offer cash prizes to the top performing students in the portfolio shows for the BFA Studio Art and BFA Graphic Design programmes.
Congratulations to Lyneisha Ince @lyneishaince and Akeome Ross respectively!
The portfolio exhibitions 'Like Big Rock' and 'Graphic Content' - as well as the Associate Degree's showcase 'Emerge' - continue from May 10th - 17th, 2024 at the Morningside Gallery and surrounding studios, BCC Campus from 11 AM - 6 PM daily.”
-Fresh Milk
https://www.facebook.com/FreshMilkBarbados

From the National Cultural Foundation.
“Calling all Visual Artists in Barbados
Here's an opportunity to submit work for display consideration in the 50th Anniversary of Crop Over!
This year's Central Bank of Barbados Crop Over Visual Arts Exhibition will be a 3-part series under the overarching theme "Diffusing Borders in Colour, Motion and For", with the 2nd instalment entitled "Contemporary Offerings“
To register, complete the form via https://ncf.bb/crop-over-visal-arts-entry-form-2024/ , no later than 4PM on Friday, June 7, 2024.

Faculty of Culture, Creative and Performing Arts ‘SHE PARADISE’ exhibition.
Opening reception Tuesday, 30 April, 6pm
Exhibition closes May 10th
Open Monday to Friday 10 AM - 4 PM
Thursday, 02 May - Friday 10 May, 2024
At The Art Gallery, Errol Barrow Centre for Creative Imagination, The University of the West Indies, Cave Hill Campus.
Fulfilment of the requirements for the BFA Creative Arts programme, The UWI, Cave Hill Campus.
For general inquiries: (246) 288 9769
A documentary film of the same name, She Paradise gets a closer look at the process and praxis of 8 select female Barbadian visual artists. In intimate interviews with Alanis Forde @alanisforde, @stricklyakilah, @iartsy_donzie, @gabriellechantel, @kadijeus, @safiastoute , @shariphoenix & @thezoekid1 the audience is urged to look beyond the idyllic and paradisal to see the works as a site of identity navigation and deconstruction of societal expectations.
Curated by délyt (Deandra Daniel) in partial fulfillment of her capstone project.




































 Limegrove Lifestyle Centre, Holetown, St James
Limegrove Lifestyle Centre, Holetown, St James





https://www.nickyhighlanderphoto.com/blog/2024/5/4/exhibition-season
Exhibition Season
May 05, 2024 in NEWS
If you've been following me for a while, you will remember that I am a member of the Barbados Photographic Society (BPS). I always recommend to photographers, both hobbyists and professionals alike, that it is always a good thing to join a club as part of your development. There are several good reasons to do so, such as:
1. Access to pooled resources and technical expertise - some clubs run any number of workshops and training specifically for beginners and sometimes offer training for small businesses
2. Safety in numbers, especially when trekking out to parts of the country that are less populated or urban areas where it is potentially unsafe to have your expensive equipment in view.
3. Camaraderie and Support - Always a good thing to meet new people, potential clients, and other like-minded individuals.
All of the above are important to help artists in general grow, not just photographers. I want to emphasize the importance of number 3 in this article.
I love going to museums and galleries in my spare time. There is something about being in a creative space that always seems to inspire me. But I must confess that I've always been scared to put my work out there for public viewing. It's one thing to shoot a photo for a friend, which they like and maybe share on their social media accounts. It is an entirely different thing to print your work and put it on display for the public. But somehow, I decided to do just that with a push from a well-meaning friend or two. Here is where the club and support connection come in. In 2023, my club decided to host its first post-pandemic exhibition entitled "20 Years of Light" in celebration of the 20th Anniversary of the Barbados Photographic Society's existence as a non-profit educational organization with the mission to foster the development of photography in Barbados. The call for submissions came in November asking for up to three images from each photographer, along with the print size options available.

My two submissions, “Self Determination” (left) and “Hands Up”, after delivery from the printer
Curated by Giselle Walker, the exhibition opened to the public on January 13 2024 to a well-attended reception at the Queens Park Gallery in Bridgetown, Saint Michael, and featured work from 24 BPS members (including myself). I entered two pieces, entitled "Self Determination" and "Hands Up", both shot in 2020 at a Black Lives Matter rally in Bridgetown. From all accounts, our work was well received by the public, with the exhibition being covered in the local newspapers and morning media. Some of the pieces were either sold or generated offers to purchase. Coming out of this experience, I even received an offer to join a second exhibition, entitled Resilience featuring work from Black, female artists in Barbados.
 Me, with “Self Determination” on archival paper 16” x 24”
Me, with “Self Determination” on archival paper 16” x 24”




LOOKA: Dismantling the Colonial Gaze: The Symposium Saturday, June 22nd, 10am-3pm.
At the Barbados Museum & Historical Society.
Admission is Free. Light lunch included
��Due to limited places, registration is required for attendance and can be completed via the provided link: https://forms.gle/JNZJSDREA5QKDZN58
An engaging symposium accompanying the exhibition LOOKA: Dismantling the Colonial Gaze at the Barbados Museum & Historical Society.
This in-person event will take place on Saturday, June 22nd, and will feature panels comprising local and international scholars in conversation with the curators and artists of the exhibition. The symposium aims to critically engage with, challenge, and dismantle colonialist perspectives on Black bodies in postcards, offering alternative visual languages that centre agency. The event will also be streamed on the BMHS YouTube channel. For further information, please contact info@barbmuse.org.bb .
We look forward to seeing you there!


The Barbados Photographic Society (BPS) is founded on an appreciation for and interest in photography.
Website
https://barphotosoc.wixsite.com/home
Email. thebarbadosphotographicsociety@gmail.com
Our Facebook Group is open to everyone with an interest in photography! You are welcome to join, share your thoughts on photography, post your work, follow the work of our members and participate in our discussions https://www.facebook.com/groups/Barbadosphoto/
Barbados Photographic Society theme for May was ‘Flowers and Foliage’ hashtag #bpsflowersandfoliage

https://www.facebook.com/groups/Barbadosphoto/



 DEANA BELLAMY
DEANA BELLAMY






 LOGAN THOMAS
LOGAN THOMAS





 REG WILSON
REG WILSON

 REG WILSON
REG WILSON

 KERRY ALARIC CHEESEBORO
KERRY ALARIC CHEESEBORO

 KERRY ALARIC CHEESEBORO
KERRY ALARIC CHEESEBORO





 MICHAEL HOAD
MICHAEL HOAD









 CARLA HINDS
CARLA HINDS


MARGARET ASHBY

 VEE HARTLAND
VEE HARTLAND







 MARTIN MCCORMICK
MARTIN MCCORMICK




 REG WILSON
REG WILSON



 JOHN WEBSTER
JOHN WEBSTER



 JOHN WEBSTER
JOHN WEBSTER
JOHN WEBSTER
JOHN WEBSTER






 RAYMOND MAUGHAN
RAYMOND MAUGHAN



















Mastering Monetization in the Creative Industry.
��To register please scan the QR code on the flyer.
“Are you an artist based in Barbados, eager to learn the secrets of turning your art into a thriving business venture? Come join Anthony White, a prominent American artist and curator, alongside Kristina Goetz, Acting Executive Director of Seattle's Artist Trust, and renowned Barbadian artist, Sheena Rose, for a comprehensive workshop on Mastering Monetization in the Creative Industry.
This in-depth session promises to equip you with the essential tools and strategies to monetize your artistic endeavors effectively.
★
Event date and time: Thurs. June 13 at 3:30 PM AST.
Limited space available! Secure your spot for this invaluable opportunity!”
- Sheena Rose

“The Division of Culture, Prime Minister’s Office, thanks the cultural community for their overwhelming interest in Culture Reset: A National Engagement.#
Since Tuesday May 7th, 2024, the Division reached the capacity of the expected registered participants.
However, since then we have been receiving a tremendous number of calls and emails from creatives who were not able to register but who still expressed a strong desire to attend.
In the vein of developing a fresh cultural policy and strategy for the people of Barbados, which is both relevant and inclusive, it is the duty of the Division to ensure that the attendees of the National Engagement represent as wide a cross section of citizens as possible.
As a result, we regret to inform you that we have had to make the disappointing decision to postpone the National Engagement. A new date, with a bigger venue will follow shortly through a subsequent announcement.
However, please rest assured that the Division will continue to engage the sector both before and after the National Engagement to ensure that this renewed energy is maintained. We thank you all for your interest!”
Divison of Culture, Prime Minister's Office
Ground Floor, East Wing
Sky Mall, Haggatt Hall
ST. MICHAEL, BARBADOS

Open Call for Artists and Photographers: from Kerry Alaric Cheeseboro.
“The KAC Gallery of Fellow Artists’ upcoming exhibition is ‘Color:BLACK’ and we are inviting creative visualists to submit their works for consideration.
The them is the color black. and we are looking for the color black to be prominently featured and be the primary focus in the artists’ works, as we hope to highlight the unique and various way the color black can visually express a mood or though, or graphically relate a specific — and even unusual — editorial.
The exhibition runs June 13 through July 7, 2024, and as we usually do, we’ll accept submissions into the exhibition run dates up until June 30.
DM us for further inquiries.”
-KAC Gallery of Fellow Artists. https://www.facebook.com/kac.gfa






Locally made crafts, jewellery, photography, sculpture and more at the ‘Barbados With Love’ Gift Shop (upstairs) at Limegrove.
Curated by Vanita Commissiong (Photography by Helen Helen)







Emancipation Village Saturday May 25th- August 17th.
Showcasing local artists, paintings, sculpture, ceramics, jewellery, craft, clothing, food, drink vand entertainment reflecting the Caribbean and Afrocentricity.
Located in Haggatt Hall, St. Michael, The entertainment will be themed to accommodate all the genres such as Afro-Caribbean dance night, theatre night, Night of Griots-poets, folk night, DJs, and more.

The Barbados Arts Council has moved to Earthworks, St Thomas.
Monday to Friday: 9am - 5pm.
Saturday: 9am - 1pm
Earthworks Pottery Complex
Edgehill Heights 2, St. Thomas, Barbados
Tel: (246) 428 2126
Email: thebarbadosartscouncil@gmail.com
Facebook: Barbados Arts Council Official Page
Instagram: BarbadosArtsCouncil
www.thebarbadosartscouncil.com
(Image courtesy of Sian Pampellonne )


“Unleash your creativity at EarthWorks Pottery
Visit their studio in Edgehill, St. Thomas, and witness the magic of master potters and painters at work.
From hands-on classes with the talented Pauline D'Hayle to exploring the latest designs, every visit is a unique experience.
Create memories, master the art of pottery, and take home your very own masterpiece!“
- Ins & Outs Barbados

Now this is a different vantage view of an art gallery.
The exhibition ‘Colours of Barbados’ now on at the Boardwalk on the South Coast.
Open 24/7.
All artwork and prints are 48” x 48” by many artists who live in Barbados.
Conceived by Mark Hiorns
The longest show. 350 feet long (and growing as artists add more pieces).
The exhibition will run for 18 months. Opened on November 29th, 2022
Organised and hosted by James Edgehill and Mark Hiorns
For more information Tel: 1 (246) 228 0631
List of Artists - Updated 7th Jan 2024
Adrian Burnett, Andrea Dennison, Anna Didier, Arianna Holligan, Catherine Cummins CherAntoinette Corbin, Cindy Walker, Hilary Armstrong, Jeena Chatrani, Julia Seymour, Kirstie Hiorns, Korena Darnelle, Kristine Dear, Linda Corbin, Maria Stanford, Mark Hiorns, Micah Rubin, Michelle Bowe, Princess Johnson, Priscilla Richardson, Providence School, Reginald Gill, Sian Pampellonne, Yasmin Vizcarrondo, Amanda Thompson, Andrew Hulsmeier, Aniya Emtage, Ann Rudder, Cathy Alkins, Chris Richards, Frank Cossey, Heidi Berger, Kristine Choy, Lorna B Wilson, Marie Elena Rose, Patrick Forde, Zak Gifford, Zoe Osborne, Sydney Inniss, Roseanne Milligan, Nicole Batson

Books: Barbados Bu'n-Bu'n - Nyam JamaicaCulinaria: The Caribbean e-books: Shake Dat Cocktail, Cocktails & Hors d'Oeuvres, Barbados Bu'n-Bu'n (4 vol), Nyam Jamaica (2 vol) (see website)
Gourmand World Cookbook Awards: Barbados Bu'n-Bu'n: Best Cookbook of the Year, Best Self-Published Book, Best Historical Recipes, Best Cookbook Design for Barbados (2014) 'Best Self-Published Book In The World' (2015) Nyam Jamaica: 'Best Design In The World' (20082009) - honoured 2015 at Frankfurt Book Fair for the 20 years of Gourmand World Cookbook Award - Best of the Best Design In The World (2015)
Caribbean Tourism Award (2009)
Barbados Bu'n-Bu'n This amazing book by Rosemary Parkinson is on island. Two hard cover coffee table books, with a sleeve that encloses both, 656 pages and 1400 plus photos filled with history, tradition, culture, stories and recipes from Barbados.
www.rosemary-parkinson.com
www.facebook.com/BarbadosCulinaryJourney

Barbados Bu'n-Bu'n, a collector's item, has won 4 awards for Barbados –Best Photography, Best Design, Best Historical Recipes, Best Self-published Book –then against 5 of the best books in the world WON Best Self-Published Book In The World and honoured at the Frankfurt Book Fair 2015 with Best of the Best In The World by the Gourmand World Cookbook Awards 2015.


Jeena Chatrani Antilles Gallery.
https://m.facebook.com/AntilleanGalleryofArt/
“Hi! Welcome To Antillean Gallery of Art!
My name is Jeena Chatrani and I recently started Antillean Gallery with the intention of promoting and selling art from Caribbean artists online.
I'm an artist myself and I've found that the art scene in Barbados could greatly benefit from some online presence. For the last 6 years I've been a full time artist and have had to learn a lot about the business behind selling art. It's not easy to make it as an artist but it is so fulfilling.
With Antillean Gallery of Art I hope to help raise the standard of art and artists in Barbados, and eventually across the Caribbean.”
-Jeena Chatrani

The artists of Antillean Gallery of Art online gallery:
Catherine Forter Chee a Tow, Cathy Cummins, Chris Richards, Dana Sikkens, Jeena Chatrani, Julia Seymour, Julianne Gill, Lorna Wilson, Mario Holder, Maurice Forde, Sian Pampellonne, Tracey Williams, Trevor Desilvia Curator Jeena Chatrani









Piece of Barbados Gallery now open at Artsplash Gallery and Cafe in Hastings.
Monday to Saturday 7am to 3pm Sunday 7am to 2pm


Helping the young talent where we can.
This pandemic has created financial difficulties for so many in the arts and they lose any chance to make a career of art.
I just received a donation of art supplies being kindly given by artist Jeena Chatrani, curator of Antillean Gallery of Art online gallery. Thank you Jeena.
These will go to a very talented 17 year old to help her keep drawing and painting.
Would you consider looking around your painting/studio space and see if there are any art supplies that you may not want or need and help the future talents of Barbados.
Either give directly to artists whom you feel may need the help or contact me via private message here and drop off the arts supplies and I will happily disburse them to those in need.
Please be aware of the dignity and pride of those receiving.
Please don’t add their names here. Private message me.
Allow them to decide if they want their names added to art supplies being given to them.
Thank you
CorrieWould you consider looking around your painting/studio space and see if there are any art supplies that you may not want or need and help the future talents of Barbados.
Either give directly to artists whom you feel may need the help or contact me via private message here and drop off the arts supplies and I will happily disburse them to those in need.
Please be aware of the dignity and pride of those receiving.
Please don’t add their names if posting. Private message me or email me at corriescott@gmail.com
Allow them to decide if they want their names added to art supplies being given to them.
Thank you
Corrie
Art supplies kindly donated to go to a young aspiring artist in need. Thank you Heidi Berger.
Helping the young talent where we can.
This pandemic has created financial difficulties for so many in the arts and they lose any chance to make a career of art.
Would you consider looking around your painting/studio space and see if there are any art supplies that you may not want or need and help the future talents of Barbados.
Either give directly to artists whom you feel may need the help or contact me via private message here and drop off the arts supplies and I will happily disburse them to those in need.
Please be aware of the dignity and pride of those receiving. Please don’t add their names here. Private message me. Allow them to decide if they want their names added to art supplies being given to them.

Books kindly donated to go to a young aspiring artist in need.
Thank you Heidi Berger Art.
Helping the young talent where we can.
This pandemic has created financial difficulties for so many in the arts and they lose any chance to make a career of art.
Would you consider looking around your painting/studio space and see if there are any art supplies that you may not want or need and help the future talents of Barbados.
Either give directly to artists whom you feel may need the help or contact me via private message here and drop off the arts supplies and I will happily disburse them to those in need.
Please be aware of the dignity and pride of those receiving. Please don’t add their names here. Private message me. Allow them to decide if they want their names added to art supplies being given to them.
Thank you
Pages that add arts events, talks, lectures, workshops, opening receptions, exhibitions, shows and more on a regular/daily basis.
Barbados Visual Arts Page (updated daily)
On Facebook https://www.facebook.com/groups/175529135827747/ On Instagram @visualartsbarbadosevents
Museum Facebook Page. Ask to be on their email listing.
https://www.facebook.com/barbadosmuseum/
Barbados Photographic Society
https://www.facebook.com/groups/Barbadosphoto/
Gine On Magazine
https://www.facebook.com/gineonmagazine/
What's On In Barbados
https://www.facebook.com/WhatsOnInBarbados/
Errol Barrow Centre page
https://www.facebook.com/ErrolBarrowCentre
Theatre Eyes
https://www.facebook.com/groups/354529934596080/
NCF page
https://www.facebook.com/BarbadosNCF/ and
https://www.facebook.com/Barbados.Crop.Over.Festival/
 Created by Lilias Gardner
Created by Lilias Gardner




Henderson Reece is well-known among art lovers for his fresh, vibrant and cheery batik creations and excels at capturing familiar local scenes and iconic elements in this globally treasured medium
He offers workshops for BB$400 for an entire day under his tutelage, which includes all materials and lunch. His protégés-for-aday leave with a batik of their own design which they can proudly mount and frame in their homes.
Thank to Ins and Outs Barbados
https://www.insandoutsb arbados.com/listing/h-p-b atik-studio

Earthworks Pottery. Mon - Fri, 9am -5pm Sat 9am-1pm

Want to paint with Plein Air Barbados arts group? Send them a message to find out when their next outdoor session will be. Please click on this Plein Air Barbados link to send them a message. https://m.facebook.co m/Bajanartists/





We're super pleased to announce that we have now started printing in house! We offer photo printing, canvas printing, fine art printing & much more. Send us your beautiful photos and we can print & frame all in one location.
Remember we also offer custom framing for your art pieces. Contact us at 271-6509 or email us at orders@frameartco.com #frameartco

Do you consider what you use and discard of regularly?
What are you doing on a daily basis to minimize your consumption of single-use plastics?



Specialising in art supplies for the professional to student level. Offering a wide range of products
Golden Paints and mediums, Gamblin, Cotman, Liquitex, Reeves, Galeria, Sargent. Plus a wide range of drawing and colouring equipment. Prisma, Derwent, Reeves, Sargent, Charcoal and Pastels.
Easels, Canvases, Watercolour paper, Drawing and Pastel paper.
Screen printing and lino block printing supplies.Fabric paint and dyes. Waxes, pottery tools, stencils and more.
Monday – Friday 8.30am – 5pm Saturday 8.30am – 3pm. Sunday Closed. Telephone/Fax (246) 436 2950
James Fort Building, Hincks Street, Bridgetown
arthub.barbados@gmail.com https://www.facebook.com/ArtHubBarbados


Our Mission
To fuel the development of culture through training, research and the creation of opportunities in cultural industries.
The NCF’s two major roles are: developmental and commercial. In its developmental role, the Foundation uses culture as a tool for national development fostering and supporting the various art forms and new cultural products. In its commercial role, the Foundation is responsible for the promotion, production and hosting of cultural festivals and associated events that are considered economically viable or socially acceptable. A key part of this function now includes the responsibility for the staging and execution of major governmental and national events. In addition, as culture becomes more pivotal to national and international policy, the National Cultural Foundation continues to re-assess its responsibilities in light of all its functions.
of the NCF are:
To stimulate and facilitate the development of culture generally
To develop, maintain and manage theatres and other cultural facilities and equipment provided by Government
To organize cultural festivals
Assist persons interested in developing cultural expression.
To provide opportunities for Barbadian artists/artistes to showcase their talents with the end result being an increased demand for local work
To educate Barbadians concerning their heritage
To offer Barbadians and visitors alike a high quality product that informs, educates and entertains
To equip our cultural workforce with technological skills and training to excel in their particular art forms
To strengthen the local cultural product and in the process increase profits to the shareholders
To create high quality products that will be competitive on the local, regional and international markets
To maximize the role of the cultural sector in the tourism industry




Deebles Point Art Gallery & Cafe. Featuring artists Frank Cossey, Trudi Johnson, Hilary Armstrong, Clermont Mapp, Nancy Cole-O'Geest, Keisha Hinds, Joshua Simpson, Claire EvansonCeppi, Keren Evanson.
Industry Hall. East Point, St Philip. Tel 423 7943
“Somewhere, amid the darkness, a painter measures a blank canvas, a poet tests a line aloud, a songwriter brings a melody into tune. Art inspires, provokes thought, reflects beauty and pain. I seek it out even more in these times. And in so doing, I find hope in the human spirit.”
Dan Rather
Very up to date on both local theatre and overseas happenings. Link here https://www.facebook.com/groups/354529934596080/964541386928262/



Purple Palm is a local business supplying homes and businesses with the highest quality Print and Mirror furnishings. Using the artwork of many local artists in Barbados and the Caribbean plus work from around the world.
We have been supplying to the hotel and villa industry for ten years, including prestigious clients such as Sandy Lane, Coral Reef, The Crane Beach Resort, Sugar Cane Club and Sandridge among others. We have also supplied numerous private villas, and work closely with local interior designers.
Being directly affiliated with a 40,000 sq ft framing factory our prices are very competitive.
Appointments to view our gallery at Rockley Resort can be made through Paul Hoad or Karen McGuire.
246-2332173 paulhoad@caribsurf.com


To boldly and brilliantly pursue the adventure in everything artistic and to be a vital and uncommon cultural force in Barbados. www.artsetcbarbados.com



FRAMING YOUR ART
FINE ART FRAMING LTD,
Pelican Industrial Park, Bridgetown, Barbados - (246) 426-5325
FAST FRAME FACTORY, Dayrell’s Road, St Michael (246) 426 9994 shaka@fastframefactory.biZ
FRAMING STUDIO
At the Best of Barbados Head Office, Welches Plantation, H’way 2A 573 6904
THE FRAME & ART COMPANY
Millhouse, Canewood • St. Michael, BB 11005 • Phone (246) 271-6509 • Cell (246) 266-9432
ART SUPPLIES
THE ART HUB
James Fort Building, Hincks Street, Bridgetown, St. Michael. Tel: 436-2950Monday - Saturday
8.30am - 5.00pm (Easy access to parking by the old Heliport Pad)
LAURIE DASH, Bay Street, Bridgetown.

GINE ON MAGAZINE·Gine On?! is the online magazine brainchild of cultural practitioners DJ Simmons & Empress Zingha published every other Thursday on GineOn.com. The husband and wife duo developed the digital publication with artists, entrepreneurs, and all the persons who support them in mind. Too many times do we hear; “Where else does events like this happen?” “Where can I hear live music?” “Anything else going on other than fetes?” “I didn't even know that was happening”. This online, access anytime hub is here; so YOU can find your next favourite time!
We broadcast bare Bajan culture to thousands of users to any device connected to the world through the web portal GineOn.com. Link with us for original video content highlighting various art personalities, new music, videos, blogs, podcasts, I mean a couple clicks opens a wealth of entertainment. We build an engaging experience for hundreds of our supporters on social media connecting the world to know wuh gine on with arts and culture right here at home. See you somewhere sometime soon...
Sign up to our mailing list to make sure you always in de know at: GineOnMagazine@gmail.com
Hosting or performing at a live entertainment event, or doing any activity progressing performing arts in the island? Forward us an email (GineOnMagazine@gmail.com) with more information so we can help push it for you. Let's help and support each other in the arts! Come and hear wuh Gine On!
https://www.facebook.com/gineonmagazine/ www.Gineon.com

Along with a constantly updated cool callendar of events, the site is basically set up in the categories Art, Crumbs & Rums, Follow Fashion, Community.
Under Arts we tell the stories of powerful cultural influencers through video Features. Highlight strong up and coming talent in Artist Peeps. Digest the experiences of stalwarts in the industry in Craftsmen Of Our Men. We link you directly to Bajans producing quality content all over the web through the page New Brand. And coming soon you will be able to attend online workshops and masterclasses in Arts Training.
Bajans love to eat and drink and through Crumbs & Rums we take you into the lives of our local farmers and vendors in Bridgetown Market. Share homegrown recipes and food & beverage blogs in Eat Bajan. Explore the diner things around here in Eating Out In Bim and link up with those street stalls who save our bellies in On De Side. Nuff content coming to fill these pages just now!
Culture is only as strong its Community. Connect with some of the most engaging Bajans through our Features. See and hear the experience patrons and performers had at events under So How It Was. Discover new places to lime and truly treasure Barbados in Part You Carring Me.
We are so fussy to announce Gine On TV. A variety of video specials with a Bajan flair. Be uniquely entertained by some of your favourite local personalities. Real Reactions, Ask Me Anything and Top Ten Talk already in production, with more right around the corner.
You know Bajans know how to take care of ourselves and in Follow Fashion Features we direct you to some the local designers in the industry. Get tips and tricks in trends, hair and body care through Looking Like A Bajan and receive online masterclasses in hair and make up through Fashion Training. This page will be filled with vibrant content very soon so make sure you subscribe for the updates. Of course our official Gine On merchandise is also available. Hats and mugs; with fitted tees and tote bags coming soon!
This site is building an archive documenting Barbadian culture to connect our passions and creativity. Make sure you hit that link to receive notifications when we post something good. Any questions, suggestions, queries or just want to send some love; contact us at gineonmagazine@gmail.com Enjoy your space to be a Bajan online and make sure you check regularly because we will be pushing out consistent content for you to enjoy. Join our social media community over at @gineonmagazine on Instagram and Facebook. Love all de time. See you somewhere sometime soon
